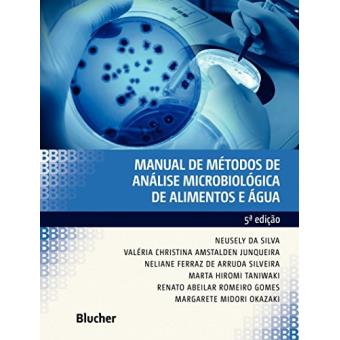
Manual de métodos de análise microbiológica de alimentos e água - 1

Manual de métodos de análise microbiológica de alimentos e água
Neusely da Silva
Desde sua primeira edição, em 1997, este livro foi preparado para fornecer um manual de métodos de análise microbiológica de alimentos em português, com metodologia aceita pela Agência Nacional de Vigilância Sanitária (Anvisa). O principal objetivo do livro é oferecer um manual ilustrado de técnicas de laboratório, com uma visão geral dos métodos disponíveis atualmente. O texto foi preparado para atender tanto a profissionais com formação acadêmica quanto a técnicos de laboratório e estudantes sem...

Resumo
Desde sua primeira edição, em 1997, este livro foi preparado para fornecer um manual de métodos de análise microbiológica de alimentos em português, com metodologia aceita pela Agência Nacional de Vigilância Sanitária (Anvisa).
O principal objetivo do livro é oferecer um manual ilustrado de técnicas de laboratório, com uma visão geral dos métodos disponíveis atualmente. O texto foi preparado para atender tanto a profissionais com formação acadêmica quanto a técnicos de laboratório e estudantes sem formação de nível superior. A configuração didática e a visualização dos procedimentos em esquemas passo a passo permitem entender e executar rapidamente o procedimento pretendido. Cada capítulo fornece vários métodos para determinado exame e alternativas simples ou rápidas disponíveis.
Avaliações dos nossos clientes
Sê o primeiro a dar
a tua opinião sobre este produto
Características
- Editora
-
Blucher
- Idiomas
-
Português do Brasil
- EAN
-
9788521212256